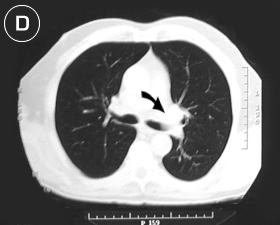
Corte Tomogr�fico

-
La disfonia con mas de 15 dias
de evolución es criterio de sospecha de lesion maligna, bien sea
en las cuerdas vocales, laringe, glándula tiroides, neoplasis pulmonares
y mediastinales.
-
Cuando la disfonia esta presente
en neoplasias pulmonares generalmente se debe a compresion del asa del
recurrente, o bien infiltración tumoral o por adenopatias infiltradas,
en la ventana aortopulmonar en el lado izquierdo y a nivel de la cava superior
en el derecho.
-
En los pacientes bronquiticos
crónicos, los cambios en el aspecto de la expectoración ameritan
particular atención, una evaluación neumonológica
constante y a la presencia de expectoración hemoptoica debemos primero
pensar que es debido a una neoplasia y posteriormente a las bronquiectasias
que suelen acompañar al bronquitico crónico. en particular
si persisten los hábitos tabaquicos.
-
El dolor en el hombro o de un
miembro superior, es una síntoma común en el tumor pulmonar
del vértice del tórax, inicialmente causado por compresión
del plexo braquial. y posteriormente por infiltración de las raíces
de los nervios del miembro superior, por este síntoma suele ocurrir
que el paciente acuda a numerosos médicos, incluyendo traumatologos,
reumatólogos y neurocirujanos quienes aplican numerosos y variados
tratamientos para aliviar su dolor y transcurre un periodo prolongado e
importante de tiempo, antes de realizar un estudio radiológico del
tórax y descubrir que se trata de una lesión neoplasica del
pulmón.
-
La bronco-fibroscopia, además
de ser un procedimiento plenamente justificado en la evaluación
y el tratamiento de pacientes bronquitico crónicos, es indispensable
para la evaluación quirúrgica de la invasión endo-bronquial
neoplasica, además de aportar el diagnóstico presuntivo o
definitivo el 70 % de los casos aproximadamente.
-
Los procedimientos de biopsia
por aspiración con aguja fina o gruesa para el diagnóstico
histologico son de utilidad en aquellos pacientes en que no se tiene un
diagnostico y están excluidos de resección quirúrgica,
bien, por lo avanzado de su enfermedad neoplasica o por otro motivo que
no justifique su intervención. Su realización en los pacientes
que van ha ser sometidos a cirugía no esta planteada por la posibilidad
de siembra de células tumorales en los tejidos en la trayectoria
de la punción.
-
La mediastinoscopia biopsia
esta indicada en aquellos pacientes que por procedimientos previos no hemos
obtenido un diagnóstico y que por tomografia torácica exista
evidencia o sospecha de nódulos ganglionares mediastinicos neoplasicos,
casos en particular en los que la cirugía de resección no
esta justificada.
-
La biopsia con aguja gruesa
o utilizando un trucut, las dejo para aquellos casos avanzados donde la
infiltración de vértebras, costillas, y deformación
de la pared costal o la presencia de metastasis es evidente y las condiciones
del paciente sean muy deplorables.
-
Cuando exista derrame pleural,
es importante verificar por citologico del liquido o histologia de la biopsia
pleural, la extensión neoplasica es criterio de irresecabilidad.
-
Como una referencia acerca del
cancer del pulmón me atrevo a sugerirles una visita fuera de mi
webSite, y en español, a la pagina de la "American
Cancer Society"
 , y no se olviden de regresar ..., hay más.
, y no se olviden de regresar ..., hay más.
|